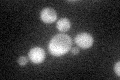
YBR214W
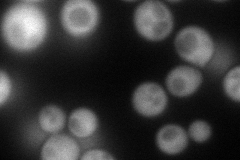
YBR214W
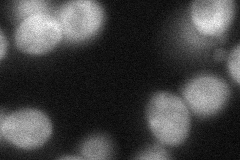
YBR214W
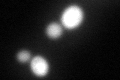
YBR214W
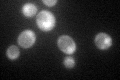
YBR214W

View description
One of two S. cerevisiae homologs (Sds23p and Sds24p) of the S. pombe Sds23 protein, which is implicated in APC/cyclosome regulation; involved in cell separation during budding; may play an indirect role in fluid-phase endocytosis
Localization:
Intensity:
Fold change:
Significance:
-
C’ GFP library in SD
cytosol40.98 -
N' NOP1pr-GFP in SD
cytosol119.55 -
N' TEF2pr-mCherry in SD

cytosol162.977 -
N' NATIVEpr-GFP in SD

below threshold19.2808 -
N' TEF2pr-VC and Cyto-VN in SD
cytosol57.7302 -
C’ GFP library in SD+DTT
cytosol82.482.01Yes -
C’ GFP library in SD+H2O2

cytosol42.631.04No -
C’ GFP library in Starvation Media
nucleusN/AN/AYes -
C’ GFP library on the background of Pup2-DaMP

cytosol -
C’ GFP library on the background of CCT mutant

cytosol53.3691.302No
